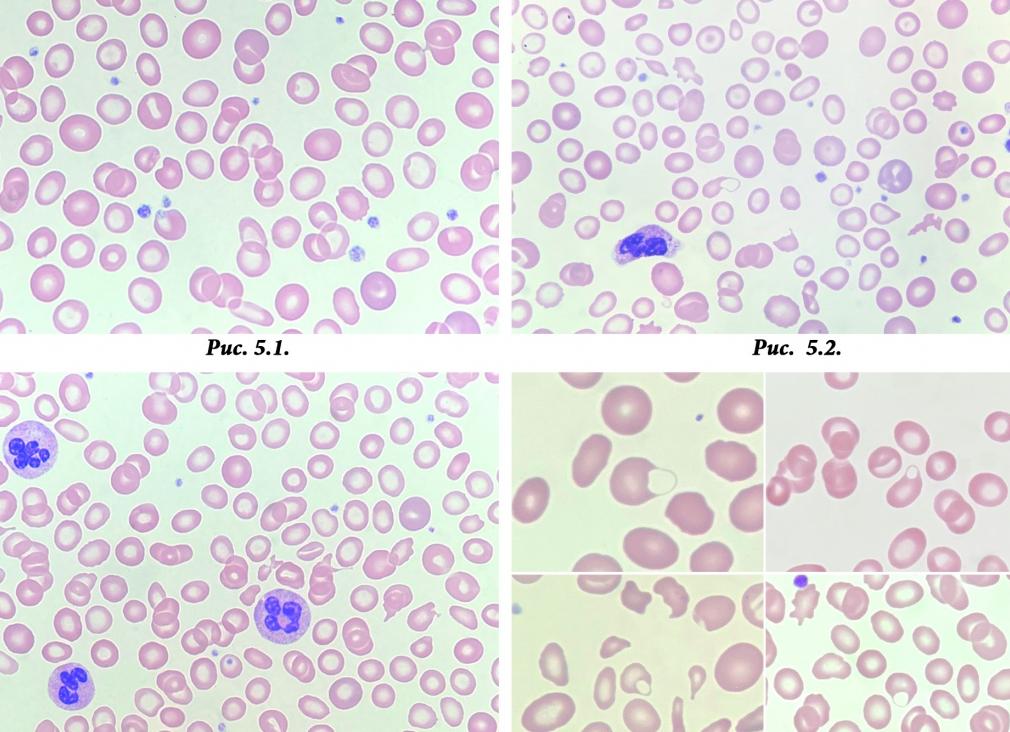
Гипохромия что это

Гипохромная анемия (гипохромия): симптомы. причины, лечение
Гипохромия – это патология, при которой в форменных компонентах крови, а именно – в эритроцитах наблюдается дефицит гемоглобина. Также ее называют гипохромной анемией. Помимо этого, с эритроцитами в данном случае происходят и другие изменения. Так, они могут стать другой формы, изменить цвет и размер. Если говорить точнее, то эритроциты при гипохромии принимают форму кольца с темными краями и светлой серединой. Гипохромная анемия – это несамостоятельное заболевание. Это общее название для 3 форм анемии. Каждая из данных патологий потребует особого лечения, поэтому нужно знать, с какой из них придется бороться. Определить это можно с помощью анализов, которые назначает врач.
Классификация гипохромии
Гипохромия классифицируется по 3 видам. Ее тип зависит от причины, которая вызвала патологию. Вот классификация данного заболевания:
Железодефицитная (микроцитарная) анемия
Такое заболевание, как железодефицитная (микроцитарная) анемия является самым распространенным из подобных патологий. Она возникает тогда, когда организм испытывает дефицит железа. Причины тому могут быть следующие:
- Любое продолжительное кровотечение, даже если произошла незначительная потеря крови. Обильная менструация также может спровоцировать возникновение железодефицитной анемии.
- Плохая усвояемость организмом железа, поступающего с едой. Как правило, это происходит в послеоперационный период, когда было хирургическое вмешательство в желудочно-кишечный тракт. Также такую ситуацию может спровоцировать постоянная диарея.
- Повышенная потребность в железе. Данная ситуация возникает в период вынашивания малыша и лактации.
- Неправильное питание. В этом случае речь идет о дефиците железа в продуктах. Как правило, такая проблема возникает у людей, отказавшихся от употребления мяса.
Сидероахрестическая анемия
Такое заболевание еще называют железонасыщенной анемией. В данном случае железо в организме присутствует в достаточном количестве. Однако организм никак не перерабатывает и не может из него выработать гемоглобин. Такая ситуация возникает, когда железо скопилось в крови после того, как произошел распад форменных клеток крови – эритроцитов. Причинами тому могут быть:
- Хронические отравления химическими веществами. Как правило, эта ситуация возникает у людей, работающих на предприятиях химической промышленности.
- Длительное медикаментозное лечение некоторыми лекарственными препаратами.
Железоперераспределительная анемия
При такой патологии железо не поступает в кровь, т.к. удерживается клетками, в которых оно содержится в достаточном количестве. Причины возникновения такой ситуации следующие:
- гнойные воспалительные заболевания;
- туберкулез;
- инфекции.
Помимо этого, анемия может быть смешанной. Это означает, что в организме развиваются сразу 2 патологии. Причинами тому могут быть, например, период обильной менструации, в который женщина решила придерживаться диеты с отказом от употребления мяса.
Симптомы гипохромии
Гипохромная анемия сопровождается следующими симптомами:
- Возникают частые головокружения. Перед глазами могут появляться черные точки. Также могут случаться обмороки.
- Появляется одышка даже после непродолжительной физической активности.
- Человек испытывает слабость.
- Сердцебиение становится частым.
- Наблюдается бледность эпидермиса, а также слизистых оболочек.
- Меняется настроение. Появляется раздражительность.
- Человек быстро устает.
Данные симптомы характерны для всех форм гипохромии. При их появлении нужно выполнить общий анализ крови. Только после этого врач может диагностировать патологию и назначить соответствующее лечение.
Как диагностируется гипохромная анемия
Такое заболевание диагностируется только во время проведения общего анализа крови. Вот, на что при этом обращают внимание:
- Содержание гемоглобина в крови. Его норма для взрослого человека составляет 120-160 г/л.
- Цветовой показатель (ЦП) крови. Его норма составляет 0,85-1,15.
Гипохромия диагностируется в том случае, если цветовой показатель эритроцитов опускает ниже 0,8. При этом определяется и степень тяжести патологии:
- 1 степень – ЦП ниже 0,8, а гемоглобин выше 90 г/л;
- 2 степень – ЦП ниже 0,8, а гемоглобин показывает уровень в районе 70-90 г/л;
- 3 степень – ЦП ниже 0,8, а гемоглобин ниже 70 г/л.
Это общие показатели гипохромии. Также следует диагностировать вид данной патологии.
Железодефицитная анемия
В общем анализе крови в данном случае выявляются следующие показатели:
- ЦП ниже 0,8;
- наблюдается гипохромия эритроцитов, они становятся кольцеобразной формы с темным ободком и светлой серединой;
- пониженный уровень сывороточного железа.
Железонасыщенная анемия
При такой патологии анализ крови дает следующий результат:
- ЦП ниже 0,8;
- наблюдается гипохромия форменных клеток крови (эритроцитов);
- сывороточное железо находится на нормальном уровне.
Железоперераспределительная анемия
Общий анализ крови в данном случае выдает следующий результат:
- уровень гемоглобина понижен;
- эритроциты гипохромные;
- сывороточное железо находится на нормальном уровне.
После диагностирования патологии назначается лечение. Если не предпринять соответствующие меры по устранению заболевания, то оно может перейти в хроническую форму. Тогда патология приведет к возникновению ряда других серьезных болезней. Также гипохромия в запущенной форме может стать причиной летального исхода.
Гипохромия у ребенка
Гипохромия может возникнуть у ребенка и даже у грудничка. Классификация для данного возраста будет такова: железодефицитная анемия и латентная. Для латентной формы заболевания характерен дефицит железа в организме без анемии. Однако чаще у детей обнаруживается железодефицитная анемия. Наиболее распространенной причиной ее возникновения является то, что ребенок испытывает дефицит железа из-за недостатка его в продуктах питания. Так, если младенец находится на грудном вскармливании, мама должна поглощать достаточное количество пищи, богатой железом.
Ребенок на искусственном вскармливании реже подвержен такой патологии, поскольку в смеси присутствуют все необходимые для нормального роста и развития вещества. Помимо этого, у грудничка она может развиться из-за раннего появления на свет или многоплодной беременности. Кроме того, гипохромная анемия у детей развивается в пубертатном периоде. Особенно это касается девочек. С началом менструации увеличивается потребность железа и если ее не удовлетворить разовьется гипохромия. Заболевание дает о себе знать частыми головными болями, быстрой утомляемостью, слабостью и т. д. Симптомы будут такими же, как у взрослого человека. Если данное заболевание оставить без полноценного лечения, то у ребенка из-за него может возникнуть патология внутренних органов, а также рахит.
Лечение гипохромной анемии
Лечение такой патологии должно происходить после определения ее вида. Если гипохромия возникла из-за дефицита железа, то пациенту назначают железосодержащие препараты. Они помогут исправить ситуацию. Также вместе с этими препаратами врач может порекомендовать специальную диету. В рационе в данном случае должны присутствовать мясо, печень, свекла, яблоки и т. д. Прием препаратов должен составить не менее 6 месяцев. Только тогда можно будет говорить о полном излечении.
Если диагностируют железонасыщенную форму анемии, то назначается прием витамина В6. Сроки лечения в данном случае определяет врач. При железораспределительной анемии сначала нужно избавиться от патологии, которая привела к ее возникновению. После этого назначается лечение непосредственно анемии. Как правило, ситуацию помогает исправить витаминный комплекс. Железонасыщенная и железораспределительная анемия не допускает терапию железосодержащими препаратами, в противном случае ситуация усугубится.
Если заболевание протекает в тяжелой форме, то в качестве лечения назначается внутривенное введение лекарственных средств. В данном случае пациент должен находиться в стационаре под присмотром врача.
Помимо этого, если гипохромия возникла на фоне открывшегося кровотечения, то первое, что нужно сделать – это остановить его. Только после этого можно приступать к лечению гипохромии.
Любая патология требует терапии и гипохромия не является исключением. Только своевременное лечение позволит избежать серьезных последствий для здоровья.
Болезнь гипохромия — что это такое?
Не все из нас могут разобраться в медицинских терминах. Например, гипохромия — что это такое? Об этом пойдет речь в данной статье.
Следует знать, что такой диагноз ставится только на основании лабораторного исследования. Итак, гипохромия в анализе крови (общем): о чем это говорит? Для начала узнаем, что означает данный термин.
Гипохромия — что это такое?
Это состояние, характеризующееся недостаточным содержанием гемоглобина в эритроцитах. Другое название этого явления — гипохромная анемия. Для установления диагноза, помимо уровня гемоглобина, изучают и цветовой показатель. При нормальном состоянии он находится в пределах 0,85-1,05 и отображает количество гемоглобина в эритроците. Если цветовой показатель составляет менее 0,8, то диагностируется гипохромия. Также данный диагноз может подтвердиться изменением размера и формы эритроцитов. При гипохромии они приобретают вид кольца, темного по краям и светлого в центре. Выделяют следующие виды гипохромной анемии:
-
железодефицитную;
-
железоперераспределительную;
-
железонасыщенную;
-
смешанного типа.
Проявления гипохромной анемии зависят от степени тяжести заболевания. Если по результатам анализов содержание гемоглобина составляет 90 г/л, то определяется первая степень тяжести, 70-90 г/л — вторая степень тяжести заболевания, ниже 70 г/л — анемия третьей степени тяжести.
Основные признаки заболевания, общие для всех гипохромных анемий:
-
головокружение;
-
одышка;
-
слабость;
-
учащенное сердцебиение;
-
бледность кожи и слизистых;
-
повышенная утомляемость;
-
раздражительность.
При появлении первых симптомов необходимо провести анализ крови, по результатам которого будет подтвержден или опровергнут диагноз «гипохромия». Что это такое, и какое необходимо лечение — подскажет опытный специалист. Главное — не затягивать с визитом к врачу и не заниматься самолечением. Так как это может стоить вам здоровья, а в некоторых случаях и жизни.
Спровоцировать гипохромную анемию могут самые разнообразные явления:
-
хронические или длительное время не прекращающиеся кровотечения;
-
нарушение всасываемости организмом железа при энтерите или в послеоперационный период;
-
состояния, при которых повышается потребность в железе (беременность, кормление грудью);
-
неправильное питание с недостаточным употреблением мяса;
-
интоксикация химическими ядами промышленного производства;
-
прием определенных лекарственных средств.
Лечение гипохромий
Терапия заболевания заключается прежде всего в устранении причины и лечении основного недуга, которые привели к данной патологии.
Если причиной гипохромии является кровотечение, то осуществляют его остановку при помощи консервативного или хирургического способа. Если патология связана с заболеваниями пищеварительного тракта, то необходимо провести их лечение. При беременности для предотвращения анемии прописывают специальные препараты железа. Если недостаток гемоглобина в организме связан с неправильным питанием, то назначают определенную диету — с повышенным содержанием мясных продуктов. Независимо от причины заболевания, пациенту прописывают препараты железа, которые необходимо принимать длительное время (до полугода). Если диагностирована тяжелая степень гипохромии, то проводят внутривенное вливание железа, эритроцитарной массы, витаминов. При выявлении железонасыщенной, так же как и при перераспределительной, анемии прием препаратов железа нецелесообразен, так как это будет способствовать накоплению лишнего железа в тканях и органах. Лечение в этом случае предполагает применение витамина В6.
Гипохромия — что это такое? Ответ на вопрос вы узнали после прочтения данной статьи.
Гипохромия что это
Гипохромная анемия (другие названия – гипохромия, или гипохромазия) – общее название для тех форм анемии, при которых из-за недостатка гемоглобина изменяется цветовой показатель крови. В лабораторном анализе на нее указывает цифра менее 0,8, а концентрация гемоглобина в одном эритроците составляет < 330 г/л.К гипохромии чаще всего приводит железодефицитная анемия и хроническое свинцовое отравление, недостаток витамина В6. Ее вызывают некоторые инфекционные и неинфекционные воспаления, при которых нарушается обмен железа (Fe) в организме.
Какие бывают гипохромии?
Согласно вызвавшим их причинам, гипохромии делят на несколько типов. Это железодефицитная; сидероахрестическая, или железонасыщенная; железоперераспределительная и смешанная анемии.
- Железодефицитная анемия. Встречается чаще всего, и, как следует из ее названия, она заключается в том, что в организме не хватает железа. Она возникает при:
- кровотечениях – массивных единоразовых или скудных, но продолжительных. Развивается у людей со скрытыми потерями крови при кровоточивости в пищеварительном тракте или из геморроидального узла. Ее регистрируют и у женщин, у которых длительные обильные месячные;
- нарушенном усвоения железа из пищи – при поносах, в послеоперационный период у людей, перенесших хирургические вмешательства на ЖКТ;
- нормальном механизме всасывания и без кровотечений, но на фоне повышенной потребности в железе – у беременных и кормящих женщин;
- недостатке железа в пище. Fe мы в основном получаем из мяса, и анемия часто бывает у вегетарианцев, которые не принимают препараты железа или продукты, богатые этим микроэлементом.
- Сидероахрестическая (железонасыщенная) анемия. В организме достаточно железа, но оно не перерабатывается и не используется для образования гемоглобина. Так происходит, если Fe накапливается в крови после распада эритроцитов. Это случается при:
- хронических химических отравлениях (например солями свинца и промышленного ядами на вредных производствах);
- из-за применения некоторых лекарственных средств.
- Железоперераспределительная анемия. Термин означает, что в организме нарушен механизм изъятия Fe из депо: клетки, которые хранят его для дальнейшего использования, «не желают» отдавать железо в кровяное русло. Развивается на фоне гнойных воспалений, туберкулеза, эндокардита и других инфекционных заболеваний.
- Анемия так называемого смешанного происхождения возникает при сочетании нескольких факторов, связанных или не связанных между собой. Сочетанными причинами могут быть беременность и недоедание, инфекционная болезнь у вегетарианца, операции на ЖКТ у человека с другим видами анемии и так далее.
Степень проявления любого вида гипохромии классифицируют согласно уровню гемоглобина в крови. На первую степень указывает цифра в пределах 90 г/л; о второй говорят при 90-70 г/л. Когда показатель падает ниже 70 г/л, диагностируют тяжелую степень.
Симптомы гипохромии
Диагноз гипохромная анемия невозможно поставить по внешним симптомам. Тип заболевания определяют только на основании лабораторных анализов. Однако все анемические состояния дают о себе знать похожими признаками, заметив которые, нужно идти к врачу и сдавать анализ крови:
- слабость, головокружение; мелькание черных мушек перед глазами, случаются обмороки;
- бледность кожи, синева под глазами («анемичный вид»);
- больные быстро устают, не могут долго заниматься ни физическим, ни умственным трудом;
- раздражительность, у женщин плаксивость без причины;
- тахикардия в покое или повторяющиеся приступы сердцебиения;
- одышка.
Косвенным образом симптоматику различных типов анемии подтверждает реакция организма на препараты Fe. Принимая их при железодефицитной форме, больные чувствуют себя лучше, при сидероахрестической их самочувствие не изменяется. При железораспределительной назначение железа также не помогает.
Диагностика и лечение
Чтобы уточнить диагноз гипохромная анемия, в лаборатории определяют уровень гемоглобина, эритроцитов в крови и цветового показателя крови (нормальное его значение – от 0,85 до 1,05). Подтверждают предварительным исследованием размеров и формы красных кровяных телец.
Нормальный эритроцит окрашен равномерно, а в данном случае он становится похож на колечко с темным ободком и светлым участком в центре. Такое состояние красных кровяных телец называется «гипохромия эритроцитов», из-за которого кровь под микроскопом выглядит бледнее, чем у здорового человека.
Анемию невозможно вылечить саму по себе, потому что она являет собой не самостоятельное заболевание, а симптом и следствие других болезней и состояний. Принимаясь за лечение, врачи ставят перед собой две задачи: устранить основную болезнь, которая вызвала недуг, и отрегулировать обмен железа в организме.
- При железодефицитной анемии терапия направлена на устранение причин потери железа и восполнение уровня микроэлемента Fe в организме. Она сочетает лекарственное и другие виды лечебного воздействия:
- при массивном кровотечении его останавливают. При обильных месячных назначают препараты для повышения свертываемости крови (либо травяные отвары, например крапивы) и другое специфическое лечение;
- хронические кровотечения из ЖКТ требуют дополнительного обследования и лечения их источника: эрозий, расширенных вен пищевода или желудка, послеоперационных осложнений;
- беременным выписывают препараты железа.
В тяжелых случаях препараты железа вводят внутривенно или переливают больному эритроцитарную массу. Железодефицитная анемия лечится длительно – не менее полугода.
- При сидероахрестической и железоперераспределительной анемии препараты Fe не нужны. При этих формах заболевания выписывают витаминные комплексы или проводят монотерапию витамином В6. Одновременно лечат воспаления и устраняют иные патологии, которые привели к болезни.
«Железосодержащая» диета
При железодефицитной анемии врачи рекомендуют есть побольше нежирного красного мяса (говядина, в меньшей степени свинина, телятина) и печень. На столе должны быть курица, индейка, куриная и индюшиная печенка, яйца. Много железа содержится:
- в морепродуктах (моллюски, устрицы, креветки, мидии), сардинах и тунце;
- в бобовых (горох, фасоль, чечевица);
- темно-зеленых листовых овощах (шпинат, все виды капусты);
- сельдерее и петрушке;
- во всех орехах и сладких сухофруктах – кураге, изюме, черносливе, финиках.
Если нет воспаления кишечника, смешайте стакан гранатового, по полстакана лимонного, яблочного и морковного соков и добавьте 70 грамм меда. Хранить «коктейль» в холодильнике, принимать в теплом виде по две столовые ложки три раза в день.
А вот людям с диагнозом гипохромная анемия других форм не стоит увлекаться красным мясом и другими железосодержащими продуктами. Железа в их организме и так достаточно, а избыток этого микроэлемента способен вызвать нарушения здоровья.
asosudy.ru
Возникновение гипохромии эритроцитов и степени данной патологии
Если выявлено наличие такого заболевания, то в результатах анализов указывается степень патологии.
Всего их три:
- Первая степень – площадь просветления эритроцита намного больше, нежели в обычной клетке.
- Вторая степень – светло-розовый оттенок наблюдается лишь на периферии клетки.
- Третья степень – из всей клетки, окрашенной частью является только мембрана, поэтому под микроскопом разглядываются кольца.
Причины возникновения гипохромии различны.
Чаще всего она появляется в следствии:
- железодефицитной анемии;
- анемии Кули;
- гемолитической анемии;
- отравление свинцом;
- некоторые другие формы анемий.
При гипохромной анемии сразу же оценивается показатель цвета крови. Практически во всех случаях он снижается и не доходит даже до 0,85 единиц, тогда как норма колеблется от 0,85 до 1,05. Гипохромии сопутствует еще одна патология – микроцитоз. При этом кровяные клетки сильно уменьшаются, что влияет на гемоглобин.
Виды гипохромных анемий
При общем анализе крови, рассматриваются следующие показатели:
- объем эритроцитов;
- уровень гемоглобина;
- окраска кровяных телец;
- структурное изменение оттенка;
- структура изменения форм.
Гемоглобин показывает, насколько тяжело протекает анемия.
Насчитывают три степени:
- Показатель гемоглобина немного больше 90 единиц;
- Отметка уровня гемоглобина падает и находится в пределах 65-90 единиц.
- Значение данного показателя немного превышает отметку в 70 единиц.
Гипохромные анемии делятся на три вида:
- железодефицитная анемия;
- сидеробластная анемия;
- железоперераспределительная анемия;
- смешанная анемия.
Первый вид встречается намного чаще остальных. По названию можно сразу понять, что пациент нуждается в железе.
Ее диагностируют по таким признакам:
- наличие в крови гипохромных кровяных телец;
- показатель железа намного ниже нормы;
- сниженный цветовой показатель;
- при приеме препаратов железа, ситуация налаживается.
К причинам возникновения железодефицитной анемии можно отнести:
- продолжительные кровоизлияния (сильная менструация, повреждения желудочно-кишечного тракта);
- плохое усвоение железа после операций, связанных с пищеварительной системой;
- потребление пищи, в которой практически отсутствует железо;
- период беременности.
Железоненасыщенная анемия – это состояние, когда железо в норме, но оно не может усваиваться в организме.
Факторы, определяющие данный диагноз:
- цветовой показатель красных клеток крови снижен;
- кровяные тельца находятся в гипохромном состоянии;
- железо в норме;
- назначение железосодержащих препаратов не дает никаких результатов.
Железоперераспределительная анемия характеризуется скоплением железа в период распада эритроцитов. Очень часто она развивается при инфекционных патологиях, воспалении внутренней мембраны сердечной мышцы или инфекционных гнойниках.
К признакам относят:
- присутствие в крови гипохромных эритроцитов;
- низкий показатель гемоглобина;
- показатель железа может быть как выше оптимального, так и в норме;
- прием препаратов железа не дает положительной динамики.
Последствия гипохромной анемии
Анемия не может угрожать жизни, но только в том случае, если ее вовремя начать лечить. Особенно это касается пожилых людей. На фоне анемии могут возникнуть различные осложнения. Вот они могут стать очень опасны и для здоровья, и для жизни.
При анемии не хватает кислорода. Когда ткани лишены этого важного компонента, возникает опасность для пациента. Вот почему активный контроль анализов крови ведется в детском возрасте, а также при беременности.
Отсутствие лечения анемии у девушек в положении отрицательно влияет на плод и может привести:
- к преждевременным схваткам и родам;
- к рождению малыша с очень маленьким весом;
- к умственной отсталости ребенка.
Для старших пациентов, страдающих анемией, характерны такие симптомы:
- спленомегалия;
- гепатомегалия;
- сильные отеки;
- покалывание конечностей;
- сбои в работе сердечно-сосудистой системы.
Каким будет лечение, зависит от причины возникновения анемии. Если в крови недостаточно железа, врач назначает курс железосодержащих препаратов, составляет определенную диету. При неэффективности таблеток, прописываются внутривенные инъекции. Критические ситуации требуют пересадку эритроцитарной массы. Продолжительность лечения может доходить до шести месяцев. Этот период не стоит прерывать.
boleznikrovi.com
Что такое гипохромия?
Общий анализ крови делается по направлению лечащего врача. Чтобы поставить точный диагноз и назначить курс лечения, ему необходимо оценить общее состояние организма.
По состоянию эритроцитов, которые окрашивают кровь в алый цвет, можно узнать многое. Если среди эритроцитов стали появляться клетки разного размера, это говорит о том, что развивается анизоцитоз.
Фото:
Когда эритроциты теряют яркость окраски, это означает, что имеет место гипохромия.
Различаются следующие виды гипохромии:
- с дефицитом железа в крови;
- с нормальным содержанием;
- слабо перераспределительная.
Специалисты отмечают еще и смешанный тип этого нарушения.
Гипохромия возникает в результате того, что нарушается механизм синтеза гемоглобина. Такое нарушение происходит по разным причинам. Одна из часто встречающихся причин – дефицит железа.
При общем анализе крови этот факт всегда выясняется. Зачастую одновременно с гипохромией диагностируется анизоцитоз.
Все явления подобного рода определяются в широких кругах населения как малокровье. Это определение верно только отчасти.
В медицине для определения такого состояния используется термин анемия. Когда в крови образуется нехватка железа, то организм не может вырабатывать эритроциты.
Диагностика гипохромии
Многолетняя практика показывает, что гипохромия, точно так же, как и анизоцитоз, выявляется при общем анализе крови. Уровень гемоглобина в эритроцитах определяет степень тяжести патологии.
Внешними признаками болезни являются слабость, головокружение, бледность кожи, быстрая утомляемость.
Функция эритроцитов заключается в том, чтобы переносить кислород, поступающий в легкие, до всех тканей организма. Основным элементом гемоглобина является железо.
Когда в крови его остается меньше нормы, то у человека начинается гипоксия клеток и головного мозга. Такое состояние в равной мере возникает как у взрослых, так и у детей.
Когда выполняется общий анализ крови, то в числе прочих параметров определяется уровень гемоглобина и цветовой показатель. Нормальным считается уровень в пределах 120 – 160 г/л.
Норма цветового показателя находится в пределах 0,85 – 1,15. Гипохромия возникает тогда, когда цветовой показатель достигает значения ниже 0,8.
При этом есть все основания предполагать, что в организме имеет место анизоцитоз. Изменение цвета кровяных телец является первым признаком заболевания.
Тяжесть заболевания оценивается по трехзначной шкале, на которой отмечен уровень гемоглобина.
Изменение цвета кровяных телец или гипохромия происходит в результате недостатка поступающего в организм железа или по причине его чрезмерной потери, которая происходит по разным причинам.
Наличие гипохромии выявляется при общем анализе крови. В числе больных подавляющая часть женщин в возрасте от 15 до 50 лет.
Недостаток железа в организме чаще всего бывает вызван при непродуманном рационе, при беременности и кормлении грудью, а также при наличии кровотечения.
Видео:
На этой почве проявляется и анизоцитоз. Цветовой показатель эритроцитов при таком состоянии менее 0,8. Прием препаратов, содержащих недостающие элементы, позволяет устранить патологию.
Иногда общий анализ крови свидетельствует о том, что гипохромия и анизоцитоз развиваются при нормальной концентрации железа.
Проблема заключается в том, что происходит нарушение механизма, по которому синтезируется гемоглобин.
Причиной гипохромии этого типа могут послужить регулярные отравления вредными веществами или сильными лекарственными препаратами с ярко выраженными побочными эффектами.
Принимать препараты, содержащие макроэлементы, в таких ситуациях не имеет смысла. Необходимо проводить глубокое исследование крови, чтобы выяснить причины, вызвавшие нарушение обмена веществ в организме.
Общий анализ крови дает возможность комплексно оценить состояние здоровья.
Многолетний опыт показывает, что гипохромия может развиваться и в том случае, когда в организме накапливаются сверхнормативные запасы железа.
Чаще всего причиной патологии является ускоренный распад красных кровяных телец. Зарождение и развитие этого процесса происходит на фоне протекания таких болезней, как гнойные инфекции, туберкулез, эндокардит.
При этом уровень железа остается в норме, а концентрация гемоглобина заметно снижается. В таком случае требуется более глубокое исследование, поскольку прием стандартных лекарств не помогает.
Лечение гипохромии
Когда гипохромия обнаружена при проведении общего анализа крови, то можно с высокой точностью определить вид анемии.
Главная цель диагностики заключается в том, чтобы выявить причины, приводящие к снижению уровня гемоглобина.
Курс лечения включает следующие этапы:
- устранение причины, вызвавшую гипохромию;
- лечение основного заболевания;
- реабилитация после основного курса.
Терапия определяется формой гипохромной анемии. Когда имеет место элементарный дефицит металла, то бывает достаточно в течение определенного периода принимать специальные препараты.
Важно придерживаться диеты, в основе которой присутствуют говядина, печень и другие продукты, богатые железом.
Если в организме нарушен механизм синтеза гемоглобина, то в первую очередь больному прописывают витамин B6. Принимать стандартные средства нет необходимости.
Гипохромия в таком случае лечится более радикальными методами – с помощью инъекций эритроцитов и витаминов.
По результатам лечения делается не только общий анализ крови, но и более углубленный. Если причиной гипохромии является кровотечение, то его следует остановить.
В таких случаях приходится применять разные методы лечения, в том числе и хирургические.
moydiagnos.ru
Что это такое
Узнав о данном диагнозе, пациент обычно задается вопросом, что это за заболевание и что собой представляет.
Признаком и причины гипохромии является низкий уровень гемоглобина – в эритроцитах крови. Поэтому они оказываются окрашены слабо (цветность меньше 0,8), изменена их структура: красные тельца похожи на кольца с темным ободком и более светлой областью внутри него.
Именно по этим признакам диагностируется гипохромия, а вследствие этого и гипохромная анемия. Это обобщенное название для нескольких видов болезни, и в каждой из них выявляются вышеперечисленные изменения в красных кровяных тельцах.
Окрашивание эритроцитов в норме и при анемии
Дефицит или перенасыщение
Природа развития гипохромии – неправильный синтез гемоглобина, нарушения в нем, причем характер этих нарушений определяет разновидность заболевания.
- Если диагностируется абсолютное понижение уровня железа – железодефицитная анемия.
При железодефицитной форме количество железа, поступающего в организм, меньше, чем требуется для нормального функционирования, расход его растет, вызывая изменения в структуре эритроцитов, понижая уровень сывороточного железа и цветности.
Этот тип гипохромии наиболее распространен, причем почти все заболевшие – это женщины, их возраст попадает в диапазон 15-50 лет, поскольку часто эту разновидность болезни выявляют у беременных и кормящих матерей. Также гипохромия эритроцитов может быть диагностирована у ребенка: новорожденного, недоношенного или в подростковом возрасте.
Помимо беременности и лактации, причинами патологии становятся сильные кровотечения и неправильное питание.
- Если гипохромия в общем анализе крови у ребенка или взрослого безусловно обнаружена, при этом результаты показывают нормальное содержание железа, но оно не всасывается и в образовании гемоглобина участия не принимает – железонасыщенная разновидность.
Клиническая картина при такой гипохромной анемии отличается от первого вида нормальным уровнем сывороточного железа при сниженном цветовом показателе и гипохромных эритроцитах. Такая форма появляется при отравлении ядами, лекарствами или химикатами, при алкогольной интоксикации. Часто диагностируется у пожилых людей.
- Если при анализе обнаружен высокий уровень железа в крови после распада эритроцитов – анемия железоперераспределительная.
Здесь наблюдается та же гипохромия эритроцитов, но на фоне нормального уровня железа и сниженного гемоглобина. Железо накапливается после скоротечного распада красных телец крови на фоне таких заболеваний, как эндокардит сердца, туберкулез, при гнойных инфекционных процессах.
Первичные признаки гипохромной анемии
Диагностика
Для всех разновидностей симптомы гипохромии практически идентичны:
- прослушивается учащенное сердцебиение,
- больной жалуется на хроническую усталость, одышку, сонливость и головокружение,
- у пациента наблюдается выраженная бледность,
- нарушение зрения (мушки перед глазами).
Точно определяется гипохромия в общем анализе (забор крови из пальца), который берется амбулаторно натощак. Для полной диагностики учитывают и количество гемоглобина в крови, и показатель цветности. У взрослых в первом случае нормальным является диапазон 120-160 г/л, во втором — выше 0,8 и до 1,15.
Выраженность вышеперечисленных симптомов гипохромии обусловлена степенью тяжести заболевания, зависящей от уровня железосодержащего белка: при 1 степени не ниже 90г/л, при следующей ступени, второй, — ниже 90 г/л, но выше 70 г/л; если уровень гемоглобина опустился ниже 70 г/л — это третья степень тяжести, и такая стадия заболевания может привести к смерти пациента.
Лечения
Лечение гипохромии второй и третьей степени тяжести должно проводиться только стационарно. Терапия обычно направлена не только на восполнение железа, но и на устранение причин, по вине которых возникли данные патологии крови.
Хороший результат в лечении первого из вышеперечисленных типов гипохромной анемии дает прием железосодержащих препаратов, но курс рассчитан на длительный период времени – до шести месяцев. Также пациенту важно соблюдать диету: сделать упор на пищу, богатую необходимым ему железом (гранаты, яблоки, печень, свекла и др.).
При железонасыщенной и железоперераспределительной формах эффект от лекарственных препаратов, содержащих железо, либо несущественен либо отсутствует совсем, к тому же они могут даже нанести вред – в организме начнется накопление ненужного количества железа.
Если выявлен железонасышенный тип, то пациенту назначается курс витамина В6. Витамины присутствуют в терапии и при железораспределительной анемии, но только в сочетании с курсом, направленным на лечение заболеваний, ставших причиной развития гипохромии и понижения уровня гемоглобина.
Необходимость в внутривенных инъекциях лекарственных препаратов и витаминов появляется только при тяжелой форме патологии. В крайних случаях для борьбы с анемией вводится эритроцитарная масса.
Хирургическое вмешательство может потребоваться при гипохромной анемии, вызванной хроническими или обильными кровотечениями, которые нужно обязательно остановить. Но это происходит только в тех случаях, когда консервативное лечение не помогает или на него уже не осталось времени.
Чтобы не доводить болезнь до тяжелой стадии и серьезных последствий для организма, важно вовремя начать лечить анемию. Важно обращать внимание на состояние своего здоровья и периодически проходить общее обследование у врача-терапевта для выявления патологии на ранних стадиях.
sostavkrovi.ru
Гипохромная анемия в анализе крови
Гипохромия, или гипохромная анемия — заболевание, а точнее ряд заболеваний, при которых эритроциты содержат малое количество гемоглобина. Но ошибочно думать, что данное состояние возникает только лишь из-за плохого питания, в котором недостает железа: случается, что нарушается всасываемость этого элемента, которого в организме в избытке. Поэтому, обнаружив в анализах сниженные показатели, не следует «налегать» на традиционное и народное лечение: вначале нужно посетить врача, чтобы найти причину и разобраться с возникшим состоянием правильно и без последствий.
Особенности заболевания
Снижение в крови человека важнейшего показателя — гемоглобина, отвечающего за перенос кислорода в ткани и выполнение окислительно-восстановительных реакций — называется анемией. Это состояние приводит к нарушению работы функционально полноценных эритроцитов, или красных клеток крови, поскольку гемоглобин находится внутри этих клеток. Чтобы гемоглобин в достаточном количестве производился в организме, необходимо соблюдение ряда условий:
- Присутствие нормального объема железа в еде.
- Оптимальное всасывание железа в желудке и кишечнике.
- Наличие белковой пищи в рационе (речь идет о животном белке).
- Достаточное поступление витамина В12, фолиевой кислоты.
- Отсутствие болезней системы крови.
Норма гемоглобина для женщин — 120-147 г/л, для мужчин — 130-160 г/л, для беременных — от 110 г/л. Когда у ребенка или взрослого в организме нарушается тот или иной процесс, касающийся поступления или всасывания железа, белка или витаминов, развивается патология — анемия. Гипохромия крови (гипохромазия, гипохромная анемия) — объединенное наименование форм анемии, при которых вследствие уменьшения гемоглобина в эритроцитах падает цветовой показатель крови, составляя менее 0,8. Гипохромия в общем анализе также проявляется снижением содержания гемоглобина в эритроците до 30 пг/л и менее, средней концентрации гемоглобина в эритроците — ниже 330 г/л.
Диагноз гипохромной, а также ее «популярной» разновидности — железодефицитной анемии — может быть поставлен на основании результатов анализа крови. Кроме стандартной расшифровки анализа по основным показателям (клеткам крови) важно оценить размер и форму эритроцитов. Они могут менять диаметр (микроцитоз или макроцитоз), обретать другую форму (пойкилоцитоз). Обычно при гипохромной анемии эритроциты становятся внешне похожими на темное кольцо со светлым центром. Данное явление тоже может стать определяющим для установления правильного диагноза. И все-таки важно и количественное определение основных показателей — гемоглобина, гематокрита, цветового показателя.
Классификация гипохромии включает несколько ее видов:
- Железодефицитная анемия. Данное состояние наиболее распространено, может наблюдаться даже у грудничка. Основные причины — хроническая кровопотеря, нарушение поступления или всасывания железа, беременность. Кроме гипохромии эритроцитов заболевание характеризуется снижением железа в сыворотке крови, падением цветового показателя, достижением положительных результатов от приема препаратов железа. В зависимости от размера эритроцитов данная анемия может быть нормоцитарной, микроцитарной, макроцитарной.
- Перераспределительная анемия. Это заболевание связано с избытком железа в сочетании с гемолизом (распадом) эритроцитов. Причины — гнойные инфекции, туберкулез и прочие воспалительные заболевания. В анализах выявляются нормальный уровень железа, гипохромия, сниженный гемоглобин, нарушение формы эритроцитов и их размера. Терапия препаратами железа неэффективна.
- Железонасыщенная, или сидероахреастическая анемия. Связана с нарушением всасывания железа в кровь при его достаточном поступлении в организм. В итоге гемоглобин синтезируется в сниженном объеме. Данная патология присуща отравлениям и интоксикациям, а также различным заболеваниям, сопровождающимся синдромом мальабсорбции. Характеристики такой анемии — снижение цветового показателя, гипохромия, норма железа в сыворотке, отсутствие эффекта от лечения препаратами железа.
- Смешанная анемия. Может сочетать в себе различные признаки анемии, но всегда сопровождается гипохромией и снижением цветового показателя.
Даже незначительная, умеренная анемия может быть опасной для человека, ведь без лечения быстро она станет выраженной. У грудничка и малыша до года она становится причиной отставания в росте, развитии, у беременной женщины приводит к дефициту веса плода и ребенка при родах. У взрослого человека гипохромия сильно нарушает работоспособность, приводит к слабости, отекам, сбоям в работе сердца и других органов, что не может не сказаться на качестве жизни и риске развития разнообразных болезней.
Причины гипохромной анемии
Существует три основных пути развития данной патологии. Первый — слишком низкое поступление железа с пищей, второй — интенсивные потери железа или усиленный расход элемента, третий — неправильное всасывание железа в тонком кишечнике. Только проведенная диагностика под контролем врача поможет разобраться в причинах болезни и изыскать пути разрешения проблемы. Непосредственные ситуации и заболевания, при которых возможно развитие гипохромии, такие:
- сниженное потребление пищи, богатой железом, авитаминозы (по витаминам группы В), скудное питание, дефицит животной пищи в рационе;
- хронические кровотечения — носовые, кровоточивость десен, маточные кровотечения, регулярные затяжные менструации, кровопотери из толстого и тонкого кишечника;
- острое массивное кровотечение (анемия легкой степени может развиваться даже при небольшой острой кровопотере или при сдаче донорской крови для переливания);
- заболевания желудка и кишечника, которые не дают железу усваиваться — синдром мальабсорбции, целиакия, болезнь Крона, энтерит, гельминтозы, острые и хронические кишечные инфекции, хронический атрофический гастрит, дисбиоз кишечника, синдром раздраженного кишечника;
- беременность, лактация, период полового созревания;
- хроническое отравление вредными веществами при работе на соответствующем производстве, чаще, тяжелыми металлами;
- нарушение производства и утилизации порфиринов;
- проведенные на органах ЖКТ операции (особенно при резекции части кишки или желудка), а также другие тяжелые оперативные вмешательства;
- затяжные тяжелые стрессы;
- злокачественные патологии крови;
- раковые опухоли, особенно, с локализацией в ЖКТ и органах брюшной полости;
- длительно текущее инфекционное заболевание, а также пиелонефрит, пневмония, туберкулез.
У детей может развиваться гипохромная микроцитарная анемия, что чаще случается из-за снижения содержания железа в депо — в специальных резервах в организме. Кроме того, гипохромия может возникать и при серьезных аутоиммунных заболеваниях, которые приводят к формированию особых иммунных комплексов с включением в них эритроцитов и к выработке антител против собственных эритроцитов. На фоне аутоиммунных анемий возникает гипохромия, а чаще это происходит у людей с такими патологиями, как системная красная волчанка, гломерулонефрит, ревматоидный артрит, системные васкулиты.
Симптомы заболевания
Выраженность проявлений гипохромной анемии во многом зависит от степени тяжести болезни. При легкой анемии симптоматика может быть вообще незаметной, только присутствует более сильная утомляемость, чем обычно, некоторое снижение работоспособности человека. У малышей уже на этой стадии может наблюдаться незначительная бледность кожи, прохладность пальцев рук и ног.
По мере прогрессирования болезни появляются следующие симптомы:
- головокружения;
- слабость;
- головные боли;
- раздражительность;
- сонливость;
- одышка;
- учащение сердцебиения;
- сильная неестественная бледность кожи;
- побледнение слизистых оболочек;
- ярко-красный, болезненный, как бы полированный язык;
- снижение давления — гипотония. Также ознакомьтесь с таблетками от давления для беременных
Уже на данной стадии следует провести анализ крови, чтобы уточнить, нет ли в нем дефицита эритроцитов и гемоглобина.
Более детальные исследования покажут присутствие гипохромии, против которой применяют различные виды терапии. Но при отсутствии помощи больному в виде необходимых препаратов и правильной диеты симптоматика может усугубляться. Появляются обмороки, серьезные нарушения работоспособности. У многих больных возникает длительный субфебрилитет без видимых причин.
Падение гемоглобина неизбежно вызывает изменения со стороны волос и ногтей. Волосы сильно выпадают, а ногтевые пластины становятся ломкими, истончаются, расщепляются и ломаются, на них появляется характерная исчерченность. Становится пересушенной кожа — она шелушится, вызывает дискомфорт при касании, порой зудит, в углах рта появляются болезненные трещины — заеды. Если гипохромия существует длительно, могут меняться пищевые пристрастия человека, которому хочется кушать совсем не пригодную для этого пищу, например, мел, уголь и т.д. На данной стадии диагностика еще более важна, ведь причин гипохромии множество, а их последствия могут быть весьма разнообразными.
Способы диагностики
Как уже было сказано, основной метод выявления патологии — общий анализ крови. В нем следует оценить гемоглобин, количество эритроцитов, цветовой показатель. Легкая степень анемии ставится при гемоглобине ниже 90 г/л, средняя степень — 70-90 г/л, тяжелая — менее 70 г/л. Гипохромия устанавливается, если норма цветового показателя (0,85-1,15) занижена. Кроме того, измеряются средний размер, объем эритроцита, количество предшественников эритроцитов (ретикулоцитов). Последний показатель поможет установить эффективность работы костного мозга.
Также критерием диагностики является обретение эритроцитами характерной формы и вида — темный окрас клетки со светлым пятном в центре. Для оценки степени реагирования организма на препараты железа (железодефицитная или железонасыщенная анемия) проводится проба с Десфералем. Обязательно делают и биохимические исследования крови, среди которых самый важный анализ — определение концентрации сывороточного железа (норма — 12-26 мкмоль/л) и общая железосвязывающая способность сыворотки (норма 42,3-66,7 мкмоль/л).
Дифференциальная диагностика проводится между различными видами анемии, которые следует отличать от гипохромии (гемолитическая анемия, аутоиммунная анемия и т.д.). Далее выявляют причину заболевания, для чего следует опросить больного на счет особенностей питания, образа жизни, выяснить факт наличия беременности, хронических патологий. Для уточнения причины и назначения правильного лечения, которое может быть даже оперативным, могут быть рекомендованы различные методы диагностики (по показаниям):
- Фиброгастродуоденоскопия желудка, двенадцатиперстной кишки.
- Пальцевое исследование прямой кишки или ректоскопия.
- Фиброколоноскопия.
- Ирригоскопия.
- УЗИ матки и яичников.
- Осмотр у гинеколога.
- УЗИ, КТ, МРТ внутренних органов.
Методы лечения
Средства лечения гипохромии могут быть различными, но начать применять их следует как можно раньше, пока не развились осложнения анемии. Обычно терапия бывает довольно длительной, не менее 2-3 месяцев, но при запущенной степени болезни она может быть еще более долгой и сложной. Одной лишь диетой избавиться от проблемы не получится, применение лекарств обязательно, так как усвоение железа из продуктов недостаточное. Из специальных препаратов этот элемент всасывается намного быстрее, эффективнее.
Чтобы избавится от анемии, необходимо начать с устранения ее причины. Обязательно корректируется основное заболевание — инфекционная патология, гинекологические проблемы и т.д. Лечение железодефицитной гипохромной анемии может включать такие методы и средства:
- Остановка кровотечения путем приема Викасола, препаратов витамина К, а, при необходимости, оперативным путем.
- Проведение операций, облучения, химиотерапии при наличии опухолей ЖКТ или другой локализации.
- Прием железосодержащих препаратов для восполнения его в организме, а также отложения в депо (запасы). Обычно лекарства дают в виде таблеток, но при тяжелой стадии болезни вводят их внутривенно. Преимущественно, назначаются лекарства Ферретаб, Сорбифер дурулес, Тотема, Фенюльс. Во многих из них есть дополнительно аскорбиновая кислота, с которой железо усваивается намного лучше.
- Гемотрансфузии — вливание в кровь больного эритроцитарной массы, полученной из крови донора. Этот метод применяется лишь в исключительных случаях и никак не влияет на причину болезни, поэтому не дает долгосрочного эффекта.
- Прием витамина В6 и его препаратов. Применяется при железонасыщенной и перераспределительной анемии, помогает усвоиться излишку железа в организме. При таких типах анемии наиболее важно лечить основные заболевания, которые становятся причиной гипохромии.
У детей и при беременности чаще всего лечение гипохромии включает прием препаратов железа, а также потребление витаминно-минеральных комплексов вкупе с нормализацией диеты. Во время лечения нужно регулярно проводить анализы крови, чтобы оценивать результативность терапии и, при необходимости, добавлять к ней прочие лекарства.
Народные средства и питание
Питание поможет насытить организм необходимым количеством белка, витаминов группы В, а также железом. Лучше всего железо усваивается из мяса (говядины) и печени, а из растительной пищи оно всасывается намного хуже. Тем не менее, исключать растительную еду нельзя, ее тоже должно быть достаточно в рационе для обеспечения больного всеми необходимыми витаминами. Очень полезна при гипохромии такая пища:
- яблоки;
- гранаты;
- свекла;
- курага;
- изюм;
- черная смородина;
- киви;
- цитрусовые;
- земляника и т.д.
Народные рецепты от анемии могут быть такими (курсы терапии — не менее месяца):
- Столовую ложку цветков клевера залить 250 мл кипятка, варить 10 минут, дать остыть. Пить по 2 ложки отвара 5 раз в сутки.
- Смешать поровну траву крапивы, траву тысячелистника, плоды шиповника, плоды рябины. Столовую ложку сбора залить стаканом воды, оставить на час, пить по 100 мл трижды в день. Применять при гипохромии, которая вызвана кровотечениями.
- Отжать сок из свеклы, моркови, черной редьки, соединить их поровну. Перелить соки в глиняную посуду, томить соки в духовке 1 час. Пить томленый напиток по 2 ложки трижды в день до еды.
- Принимать каждый день по 2 стакана смеси из соков граната, яблока, моркови, в которые добавлена ложка меда.
- Соединить по 200 г какао-порошка, топленого свиного сала, сливочного масла, меда. Растопить все ингредиенты, кроме меда, на огне, хорошо смешать, остудить, вбить в средство мед. Употреблять по чайной ложке трижды в день во время трапезы.
Чего нельзя делать
При гипохромной анемии, как и при других разновидностях болезни, не следует употреблять большое количество продуктов, богатых кальцием. Он не дает железу полноценно усваиваться в крови. Молочные продукты не стоит потреблять вместе с мясом, железосодержащими фруктами, лучше есть их отдельно и не злоупотреблять ими. Нельзя запивать таблетки с железом чаем, кофе и иными напитками, кроме воды: они не дают препарату всасываться в полной мере. От жареных, слишком жирных блюд в диете лучше отказаться, предпочтя правильное, здоровое питание.
Профилактика патологии
Для профилактики гипохромной анемии важно не допускать хронических кровопотерь, вовремя лечить все инфекционные болезни, правильно и полноценно питаться, при необходимости, пить витамины и минералы в комплексах, а также препараты железа. Важно также регулярно проходить обследования у врача и сдавать кровь на анализ, чтобы вовремя выявить анемию и вылечить ее без последствий.